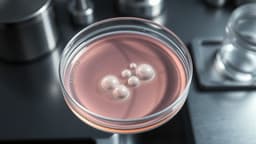
article image

Home / Crime and Justice / Raisen Rape Case: Opposition Slams State Govt Delay
Raisen Rape Case: Opposition Slams State Govt Delay
28 Nov, 2025
Summary
- Opposition leader criticizes state government's inaction on a recent rape case.
- Accused in Raisen minor rape case remains absconding despite protests.
- Victim receiving treatment; police teams are actively searching for the accused.

Madhya Pradesh's Leader of Opposition, Umang Singhar, has voiced strong condemnation against the state government, citing the ongoing delay in apprehending the suspect in a disturbing rape incident involving a six-year-old girl in the Raisen district. Singhar expressed deep concern, stating that the government's focus on meetings has not led to the accused's capture.
Alleging a pattern of failure in maintaining law and order, Singhar highlighted this recent case as another instance of the government's inadequacy. He questioned the ministers' and officers' empathy for the victim's family, emphasizing the shame brought upon the state by the slow progress in justice. Locals have also staged protests, demanding immediate action.
The incident, which occurred on November 21, involved the accused luring the minor with sweets and assaulting her in a forest area. The victim was hospitalized and is receiving medical care. Police have registered a case and are deploying multiple teams to locate and arrest the suspect.